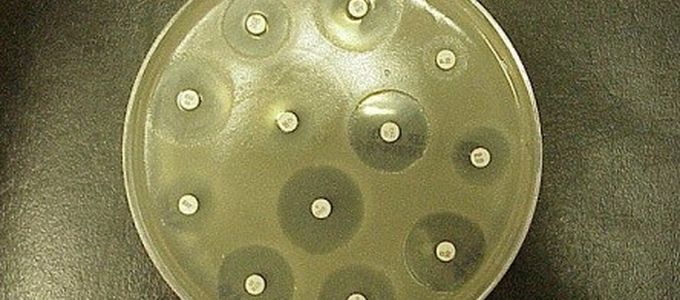
Prudent Use of Antibiotics

Global pharma is set for a strong year again at CPhI Worldwide held in Madrid, Spain with a record 164 countries and 44,500 attendees.
Huvepharma® Italy focused attention on their EU produced API portfolio at this year's event.
In total, CPhI Worldwide, along with bioLIVE, ICSE, FDF P-MEC and Innopack, featured 22 country pavillions and 19 different zones covering the entire pharma supply chain. Over 4000 attendees watched the sessions presented throughout the event which included a who's who of prominent executives and exports exploring the future of the industry. The agenda included keynote speeches on:
- quality by design
- introduction and implementation of continuous manufacturing
- smart packaging
- digital future of pharma


about us
Huvepharma®
Change country
The Huvepharma® distribution network covers 90 countries in 6 continents. Please select a country from the list below to see the products and services available in that region.
To view all products and services, select Global from the dropdown menu or click .
Change language
Huvepharma has a remarkable distribution network which covers 90 countries in 6 continents. To offer you the best services, we ask you to select your country.
Europe
Your browser is out of date!
Update your browser to view this website correctly. Update my browser now